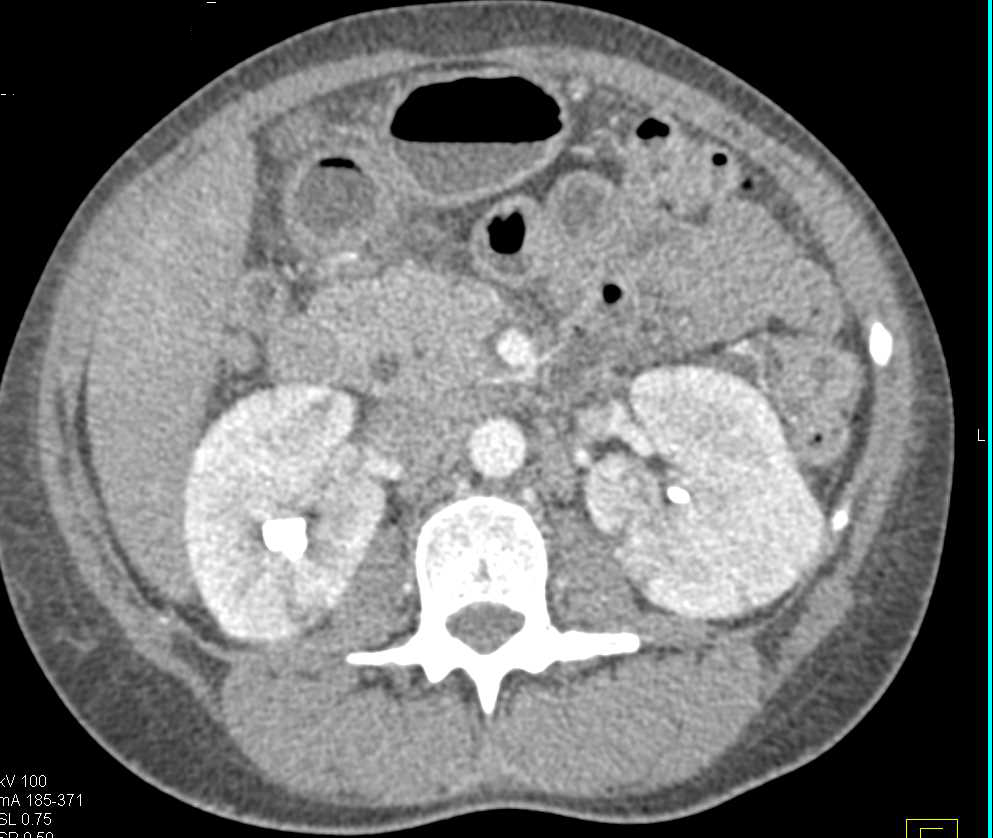

- 5
- 1
- ,
- 5
- 7
- 4
To Quiz Yourself: Select OFF by clicking the button to hide the diagnosis & additional resources under the case.
Quick Browser: Select ON by clicking the button to hide the additional resources for faster case review.
CASE NUMBER
7,023
Diagnosis
Horseshoe Kidneys with Infarcts
THIS IS CASE
7,023
OF
7,768